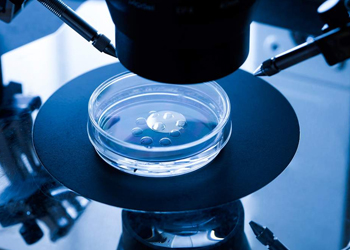

Our Doctor's team with IVF staff




Successful fertility treatment is all about team work from the first consultation right through to the treatment process and after wards, an experience highly skilled and committed team is here to ensure the best possible advice treatment and care.
In the background our embryologist and technical staff apply equal Dedication everyone at TNTBC committed to your success.

Can be done by any relative or friend, Anonymous egg donation available., Very reasonable remuneration to the donor. Read More

The couple undergoes IVF+ICSI treatment in the usual way. When embryos are transferred in to the uterus of a host surrogate Read More

Anything which occurs outside the body is called, in vitro and when fertilization of egg with sperm occurs out side the body it is called Read More

The process of putting the best lot of specially prepared sperm directly inside the uterus at the expected time of ovulation egg release is called Read More

Technique of injection of one sperm in to the cytoplasm of one oocyte for fertilization of one oocyte is called intra cytoplasmic sperm Read More
Successful fertility treatment is all about team work from the first consultation right through to the treatment process and after wards, an experience highly skilled and committed team is here to ensure the best possible advice treatment and care.
In the background our embryologist and technical staff apply equal Dedication everyone at TNTBC committed to your success.

A Dynamic obstetricion and Gynaecologist Graduated M.B.B.S from K.A.P.V. Govt Medical College, Trichy, Post Graduate from Madurai Medical College.

An young and energetic Diabetologist, clinical microbiologist, graduataed his MBBS and MD in Medical Microbiology from Thanjavur Medical College . Completed Diploma in Diabetes, PG Diploma in infection diseases followship in primary care pediatrics.

Senior Physician and cardiologist of our hospital. Experianced in intensive care therapy.

Senior Physician and cardiologist of our hospital. Experianced in intensive care therapy.

Senior Anaesthetist renowned in town. skillful in managing emergency obstetrics.

Senior Anaesthetist renowned in town. skillful in managing emergency obstetrics.

An experienced general surgeon Graduates his UG and PG from Thanjavur Mediacl College

An enthusiastic pediatrician cum neonatologist graduated MBBS from Thirunelveli Medical College, PG from ICH, Chennai.

An experienced psychiatrist giving counselling for infertile couples.

Senior Embryologist trained in kamini Rao Hospital, Bangalore. Regularly coming to our centre for IVF batches Experience hands in ICSI.

Visitors counter
An experienced senior obstetrician and Gynaecologist cum infertility specialist. Graduated her M.B.B.S and D.G.O from Thanjavur Medical College. Got trained in GG Hospital, chennai. Experienced hands in laporoscopy and hysteroscopy.